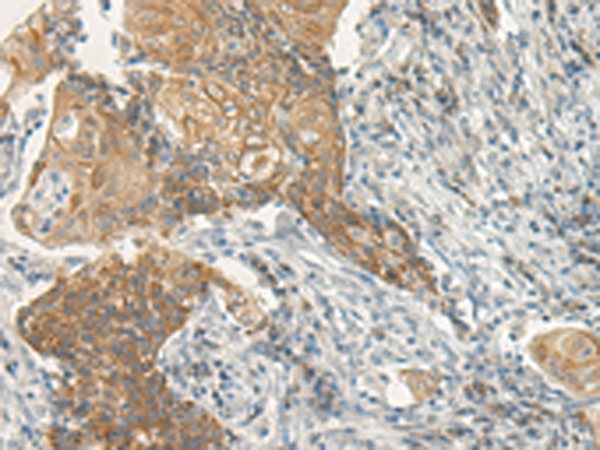

-
分类: 科研抗体货号: P05451别名: GOA; RNF100应用: IHC反应种属: Human, Mouse
-
分类: 科研抗体货号: P05449别名: RAPA; BCAR2; TREP132; TReP-132; HSA277276; dJ139D8.5应用: IHC反应种属: Human, Mouse
-
分类: 科研抗体货号: P05507别名: VPAC2; VPAC2R; VIP-R-2; VPCAP2R; PACAP-R3; DUP7q36.3; PACAP-R-3; C16DUPq36.3应用: IHC反应种属: Human, Mouse, Rat
-
分类: 科研抗体货号: P05447别名: MRD61; ARC250; THRAP1; DRIP250; HSPC221; TRAP240应用: IHC反应种属: Human, Mouse
-
分类: 科研抗体货号: P05445别名: TGMZ应用: IHC反应种属: Human
-
分类: 科研抗体货号: P05506别名: II; HVR1; RDC1; V1RG; VIPR; VIRG; VAPC1; VPAC1; VPAC1R; VIP-R-1; VPCAP1R; PACAP-R2; PACAP-R-2应用: WB,IHC反应种属: Human, Mouse, Rat
-
分类: 科研抗体货号: P05443别名: TANGO13A应用: WB反应种属: Human, Mouse, Rat
-
分类: 科研抗体货号: P05505别名:应用: WB,IHC反应种属: Human, Mouse, Rat
-
分类: 科研抗体货号: P05441别名: NTPH; ADHD7应用: IHC反应种属: Human, Mouse, Rat
-
分类: 科研抗体货号: P05504别名:应用: IHC反应种属: Human, Mouse

鄂公网安备42018502007531号
鄂公网安备42018502007531号

